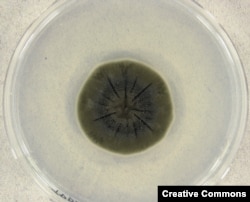
Cladosporium sphaerospermum – არის სწორედ ჩერნობილის შავი სოკო, მოთავსებული პეტრეს ჯამში.

ახალ წელს ვეგებებით, ძველს ვაცილებთ და თითქოს 2020-ის დავიწყება გვინდა, მაგრამ ამ წელს მოხდა კარგი ამბებიც, რომლებიც დაჩრდილა არასასიამოვნო ცნობებმა, მაგრამ ისინი დავიწყებას ვერ მიეცა.
ენერგიის ახალი წყარო: თერმობირთვული სინთეზი შეცვლის სამყაროს
მკვლევართა ოცნება შეექმნათ სუფთა თერმობირთვული რეაქტორები, რომლებიც შეძლებდნენ ქალაქები მოემარაგებინათ ენერგიით, ოდნავ მიუახლოვდა რეალობას აგვისტოში, როცა საფრანგეთის პრეზიდენტმა, ემანუელ მაკრონმა, გამოაცხადა საერთაშორისო ექსპერიმენტული თერმობირთვული რეაქტორის აგების შესახებ. მართვადმა ბირთვულმა სინთეზმა შეიძლება რევოლუცია მოახდინოს მსოფლიო ენერგეტიკაში.
ატომის ბირთვის გახლეჩის რეაქციისგან განსხვავებით, როცა გამოიყოფა უზარმაზარი ენერგია, რომელსაც მიწასთან შეუძლია გაასწოროს ხიროსიმა, ბირთვული შერწყმის დროს გახურებული ნაწილაკები ვაკუუმში ეჯახება ერთმანეთს და მათი შეერთებით წარმოიქმნება უფრო დიდი ატომი. ამგვარად მიღებული ენერგია არ არის დაკავშირებული მავნე ნივთიერების ნარჩენებთან და, ამასთან, პროცესი პრაქტიკულად უსასრულოა. რეაქციისთვის საჭიროა მცირე რაოდენობის საწვავი, მისი მოპოვება ნაწილობრივ ზღვის წყლიდანაც შეიძლება.
ამ პროექტის გარშემო პირველად ილაპარაკა საბჭოთა ლიდერმა, მიხაილ გორბაჩოვმა აშშ-ის პრეზიდენტ რონალდ რეიგანთან შეხვედრისას 1985 წელს.
მას მერე პროექტს შეუერთდნენ სხვა ქვეყნებიც და დიდი თანხები იქნა დახარჯული. რეაქტორის გამოცდა დაგეგმილია 2025 წლისთვის.
პროექტის შენელებული ტემპით განვითარებამ ბევრ ორგანიზაციას უბიძგა ცდების ჩატარებისკენ თერმობირთვული სინთეზის კამერებში, რის თეორიული დასაბუთება უკვე 50-იან წლებში წარადგინეს საბჭოთა ფიზიკოსებმა. როგორც უნდა იყოს, წარმატების შემთხვევაში ენერგიის წვდომის პრობლემა თვალსაწიერ მომავალში შეიძლება გახდეს შესაძლებელი.
"ჩერნობილის სოკო" დაიცავს ადამიანს კოსმოსური რადიაციისგან
სტენფორდისა და ჩრდილოეთ კაროლინის უნივერსიტეტის მკვლევრებმა გამოაქვეყნეს სტატია იმის შესახებ, რომ სოკო, რომელიც ჩერნობილში გავრცელდა, შეიძლება დაეხმაროს კოსმონავტებს მარსზე გადასხდნენ და იქ უსაფრთხოდ იცხოვრონ.
ეს მონაცემები გამოქვეყნდა მას მერე, რაც მკვლევრებმა, რომლებმაც მოინახულეს ჩერნობილის ატომური სადგური, ყურადღება მიაქციეს შავ სოკოს, რომელიც დასხივებული ზონის შიგნით გამრავლებულიყო.
შემდგომი კვლევებით დადგინდა, რომ ჩერნობილში გამრავლებულ სოკოვან ორგანიზმს (ამ ჯგუფს ექსტრემოფილს უწოდებენ განსაკუთრებულ გარემოში გამრავლების უნარის გამო) აქვს შესაძლებლობა გადაამუშაოს რადიაცია ენერგიად და ამით მოახერხოს ატომური ელექტროსადგურის პირობებში გამრავლება. რადიაციისადმი ასეთმა ლტოლვამ მიიყვანა მეცნიერები მოსაზრებამდე, რომ სოკოს ნიმუში საერთაშორისო კოსმოსურ სადგურზე გაეგზავნათ.
ერთ-ერთი მთავარი პრობლემა მარსზე ადამიანის გადასმისას იქნება კოსმოსური რადიაცია, რომელიც დედამიწის ატმოსფეროს გარეთ პრობლემას წარმოადგენს კოსმონავტებისთვის. NASA ძალიან იყო დაინტერესებული დაედგინა, როგორ იქნებოდა ამ ორგანიზმის მოქმედება კოსმოსში.
კოსმოსურ სადგურში უშუალოდ რადიაციის სენსორთან გაახარეს Cladosporium sphaerospermum-ი და შექმნეს მისი 1,7-მილიმეტრიანი „გაზონი“. სოკომ შთანთქა რადიაციის 2 პროცენტი. ეს მცირე რიცხვად შეიძლება მოგეჩვენოთ, მაგრამ სტატიამ ფურორი მოახდინა სამეცნიერო წრეებში. წერილის ავტორების დასკვნით, თუ სოკოს ფენას გავზრდით 21 სანტიმეტრამდე, კოსმონავტები მთლიანად იქნებიან დაცული რადიაციისგან.
აღმოჩენა განსაკუთრებით ბევრს ჰპირდება მეცნიერებს, თუ მარსზე ან „წითელი პლანეტისკენ“ მიმავალ კოსმოსურ ხომალდზე შეძლებენ სოკოს გამრავლებას.
ათი მილიარდი ხის დარგვის ინიციატივა - პაკისტანელი მუშებისთვის გადარჩენის საშუალება
60 ათასადე პაკისტანელმა მუშამ, რომლებიც უმუშევრად და შემოსავლის გარშე დარჩნენ კორონავირუსის პანდემიის გამო, ახალი საქმე ნახეს ხეების დარგვის სახით.
2018-დან 2023 წლამდე პაკისტანის ტყეების აღდგენის მიზნით 10 მილიარდი ხის დარგვის ინიციატივა პანდემიის დაწყებისთანავე მიავიწყდათ, ამ ქვეყნის ეკონომიკამ კი უკანსვლა დაიწყო. მაგრამ მთავრობის გადაწყვეტილება შეეჩერებინათ ხეების დარგვა, გაუქმდა, ხოლო მუშები, რომლებიც უხელფასო შვებულებაში გაუშვეს, კვლავ დასაქმდნენ.
მუშები, რომლებსაც შიმშილით სიკვდილი ემუქრებოდათ, ახლა ყოველდღიურად 500 რუპიას - დაახლოებით, სამ დოლარს - იღებენ. ერთ-ერთმა მათგანმა „როიტერსის“ სააგენტოს უამბო, რომ ისინი ახლა ყოველდღიურ ჯამაგირს იღებენ, რაც ბევრმა დაკარგა. ხეების დარგვის ინიციატივა, მისი თქმით, ნიშნავს, რომ ახლა შეუძლიათ „ყოველდღიური ხელფასის მიღება და ოჯახის გამოკვება“.
ქარის ელექტროსადგურის გაფერადებული ფრთა ბევრად უფრო უსაფრთხოა ფრინველებისთვის
ნორვეგიელმა მეცნიერებმა მიაგნეს მეთოდს, როგორ აიცილონ თავიდან ქარის ელექტროსადგურთა ტურბინების ფრთებთან შეტაკებისას ყოველწლიურად ათასობით ფრინველის დაღუპვა.
ივლისში გამოქვეყნდა სტატია, რომელიც აღწერს სმიოლის ქარის ელექტროსადგურების მრავალწლიან გამოცდილებას ამ საქმეში. სტატიის ავტორების თანახმად, დახოცილი ფრინველების რიცხვი საგრძნობლად შემცირდა მას მერე, რაც ზოგიერთი ტურბინის ერთ-ერთი ფრთა შავად შეღებეს.
ფრინველების დახოცვის თემა ქარის ენერგეტიკის მოწინააღმდეგეთა ერთ-ერთი მთავარი არგუმენტია. ფრინველები განსაკუთრებით დაუცველები არიან ტურბინის სწრაფად მოძრავი ფრთების წინააღმდეგ, რადგან ნისლიან ამინდში ისინი ვერ არჩევენ მას გარემომცველი ცისგან.
კვლევის დაწყებამდე სმიოლში რამდენიმე ბოლოთეთრა არწივი ნახეს ტურბინებთან შეტაკების შედეგად მკვდარი.
მკვლევრებმა მაძებარი ძაღლების გამოყენებით, რომლებიც პოულობდნენ დახოცილი ფრინველების ძვლებს ქარის ელექტროსადგურებთან, დაადგინეს, რომ ტურბინების ფრთის შავად შეღებვის შემდეგ დახოცილი ფრინველების რიცხვი 70 პროცენტით შემცირდა.
აშკარაა, რომ ფრინველი უკეთ ხედავს შავ ფერს და თავს არიდებს საშიშ ზონას. ამასთან, უნდა დადგინდეს, ხომ არ ეხება ასეთი შედეგი მხოლოდ ამ რეგიონს და ფრინველების ამ სახეობებს. ანალოგიური ცდების ჩატარებას ფიქრობენ სამხრეთ აფრიკის რესპუბლიკასა და ნიდერლანდში.
ვიეტნამი წარმატებით ებრძვის გარეული ცხოველებით უკანონო ვაჭრობას
დაიწყო თუ არა კორონავირუსის პანდემია, რომლის წყარო, ზოგიერთი მონაცემებით, ჩინეთის გარეული ცხოველების ბაზარი იყო, ვიეტნამმა აქტიური ბრძოლა გააჩაღა ცხოველთა უკანონო ვაჭრობის წინააღმდეგ. ეს ქვეყანა ადრე ერთ-ერთი მთავარი ტვირთგადასაცლელი პუნქტი იყო ამ მხრივ.
ივლისში გავრცელდა მოულოდნელი ცნობა, რომ ვიეტნამი კრძალავს გარეული ცხოველებით ვაჭრობას, რათა მომავალში ახალი დაავადებების საფრთხე შეამციროს.
თვითონ ვიეტნამში საქმეში ჩახედული პირები ფიქრობენ, რომ ეს ასე არ არის: მთავრობამ, უბრალოდ, მოითხოვა არსებული კანონების შესრულება, თუმცა, პანდემიის ფონზე, ეს მოთხოვნა მხოლოდ ფუჭი სიტყვები არ არის.
ეკოლოგების თანახმად, ბოლო ორ წელიწადში ვიეტნამში გამოვლენილი ბრაკონიერების რიცხვი 44 პროცენტით გაიზარდა, ხოლო 2020 წელს გამოვლენილი ბრაკონიერების 97 პროცენტი დააპატიმრეს. მკაცრად იდევნება კანონდამცველების მიერ ასევე გარეული ცხოველებით ვაჭრობა.